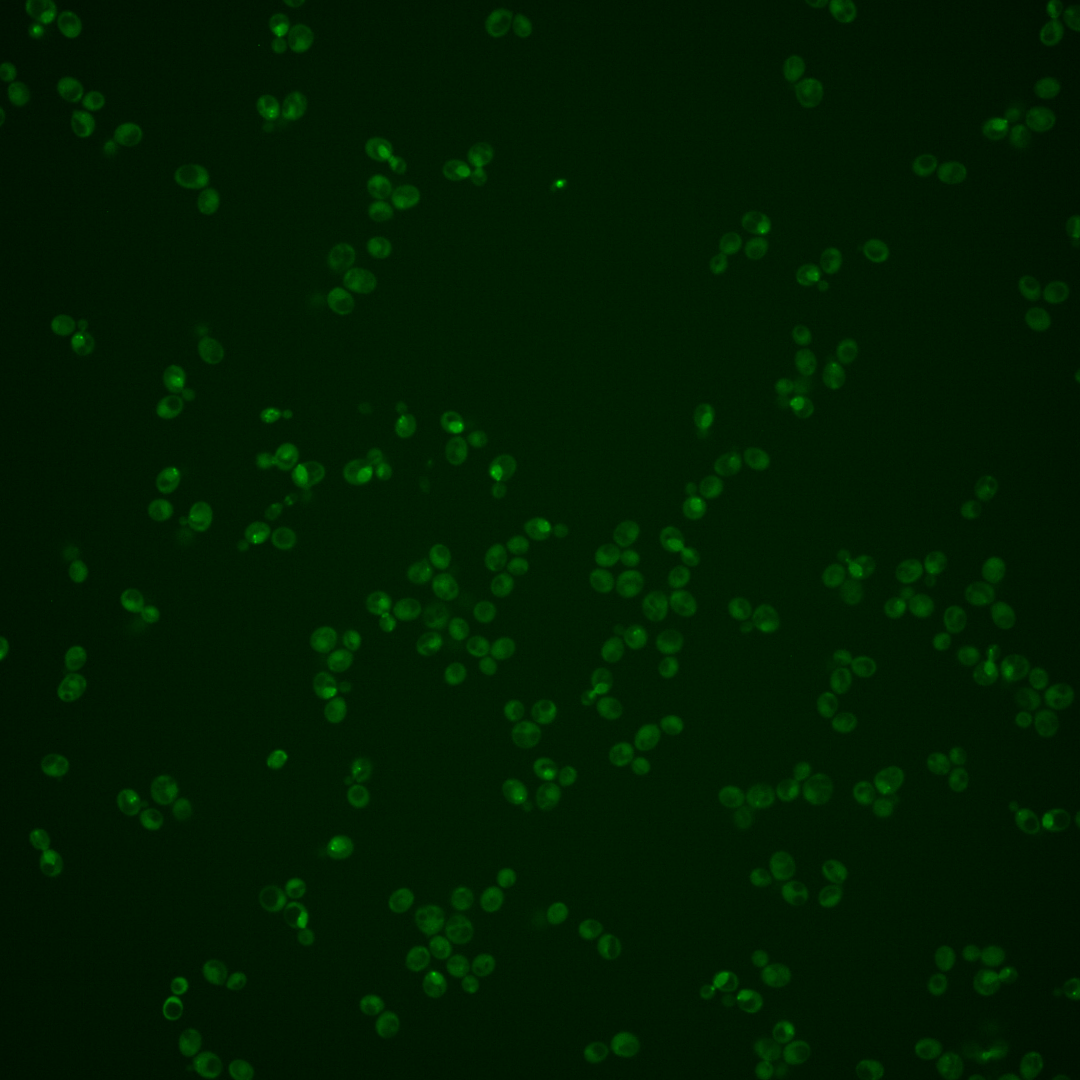
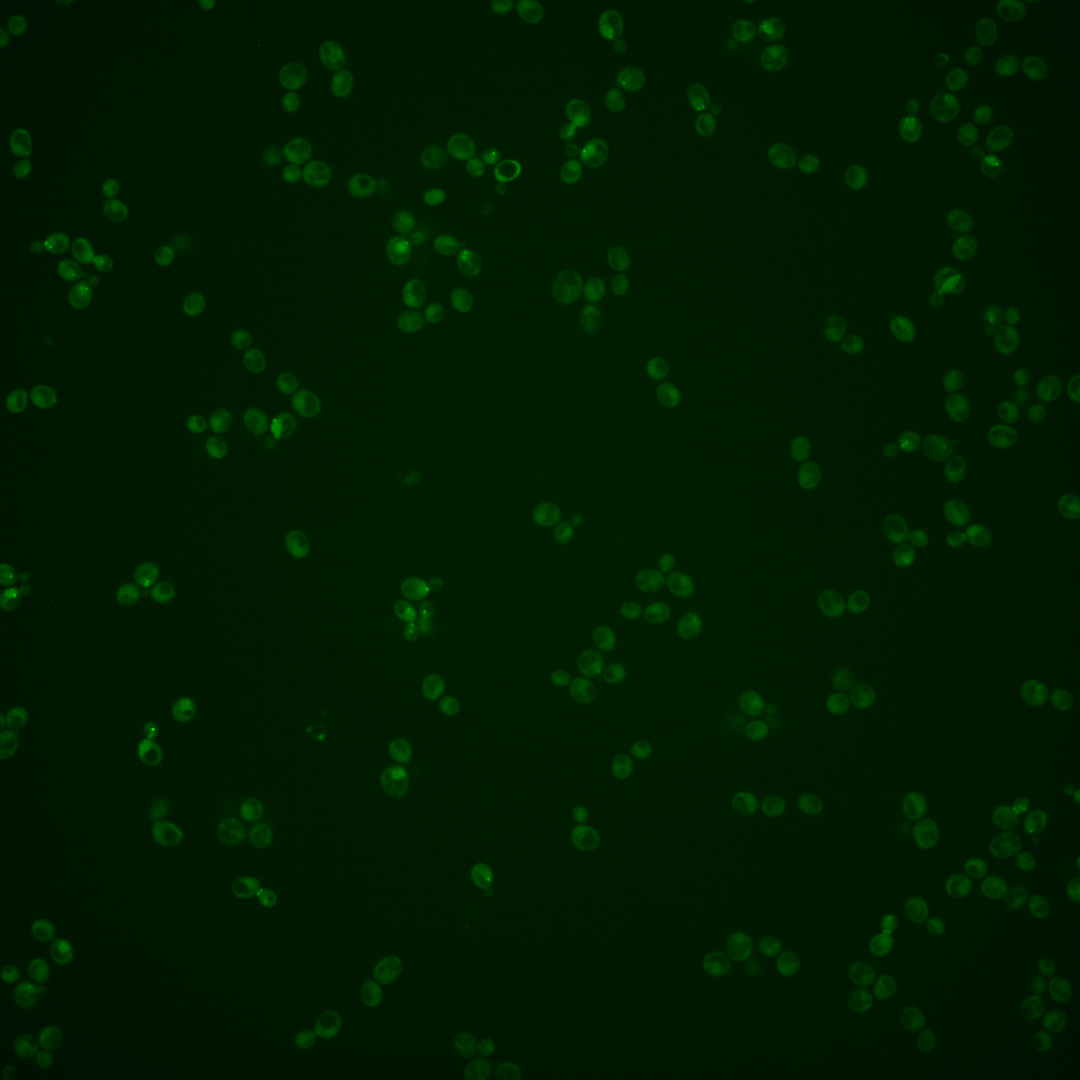
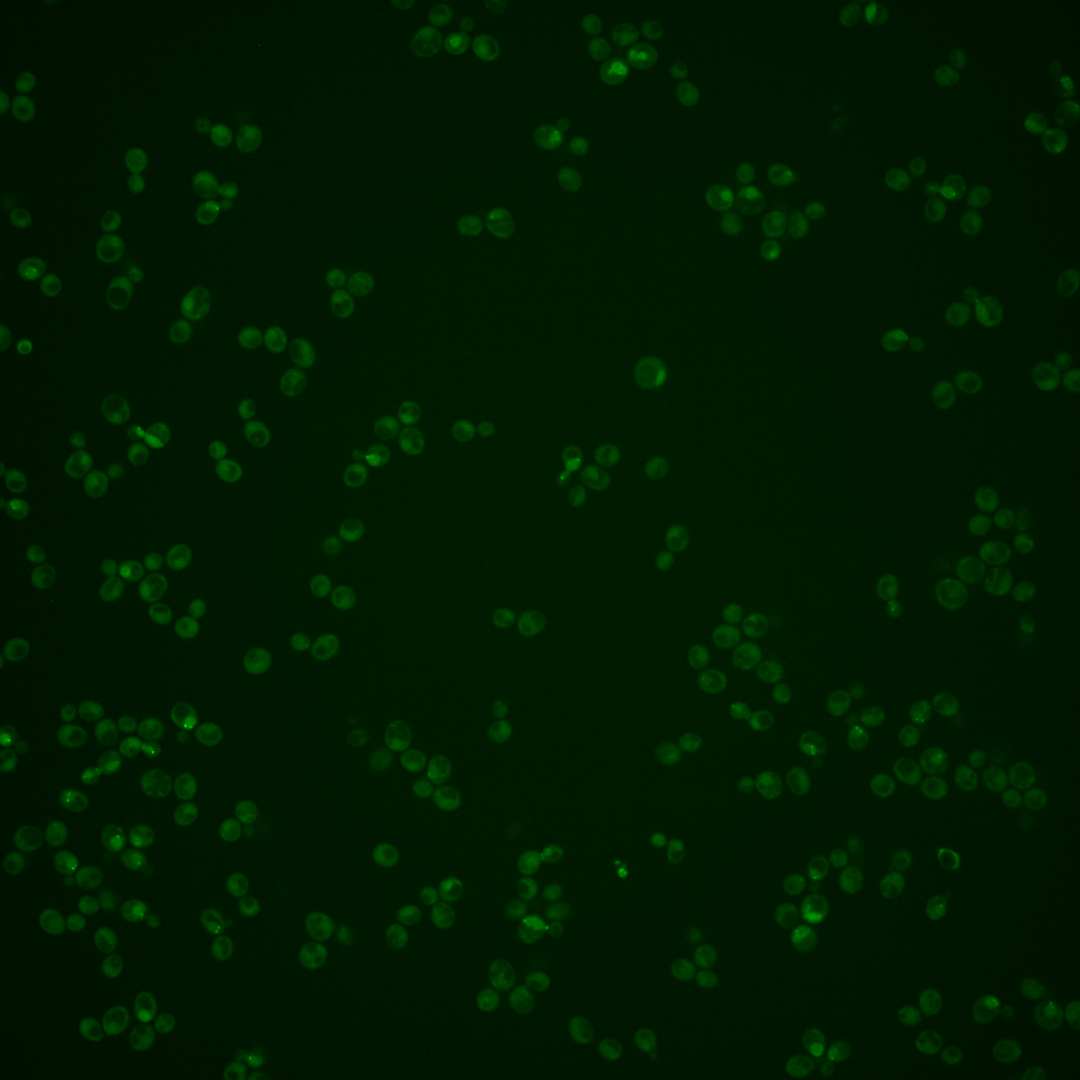
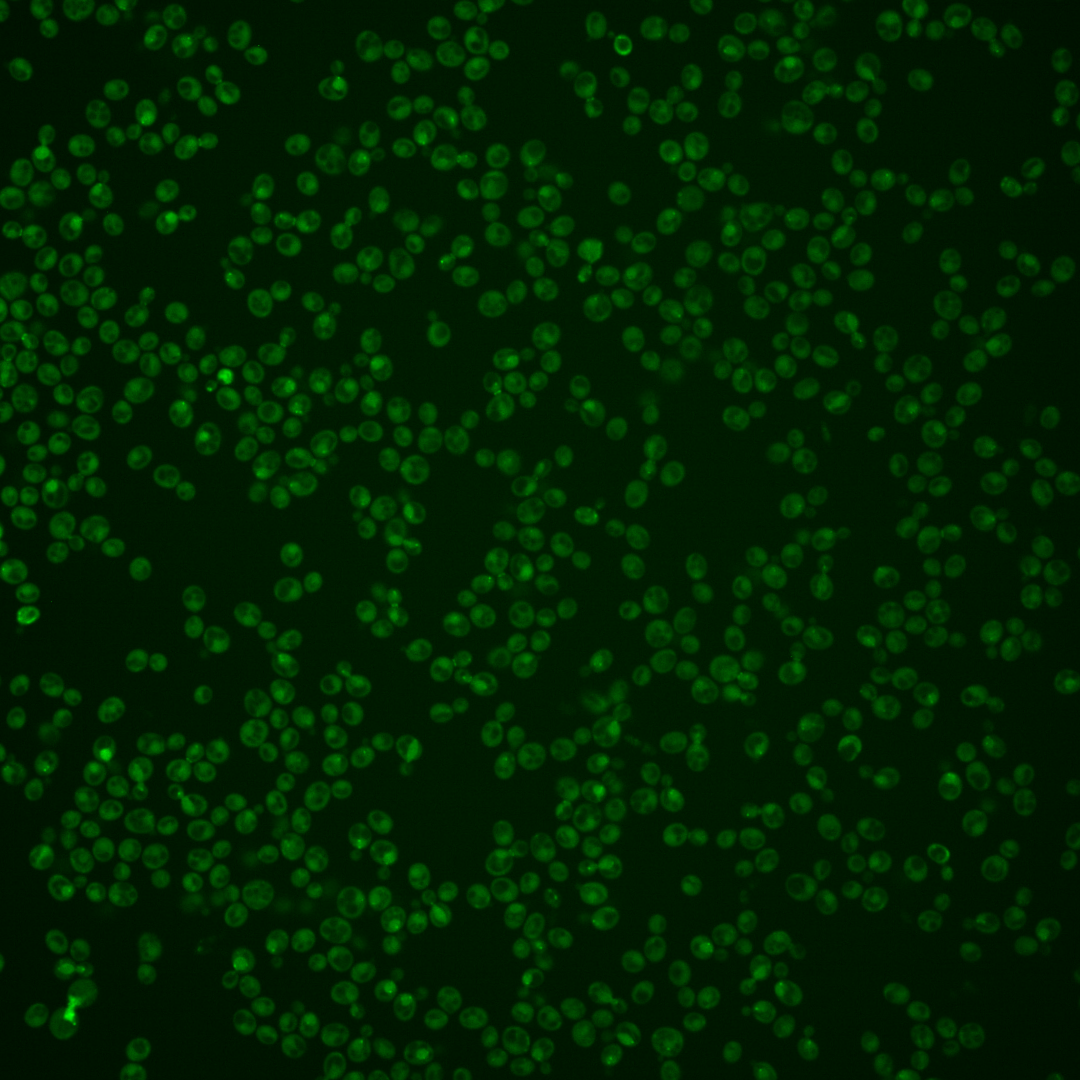
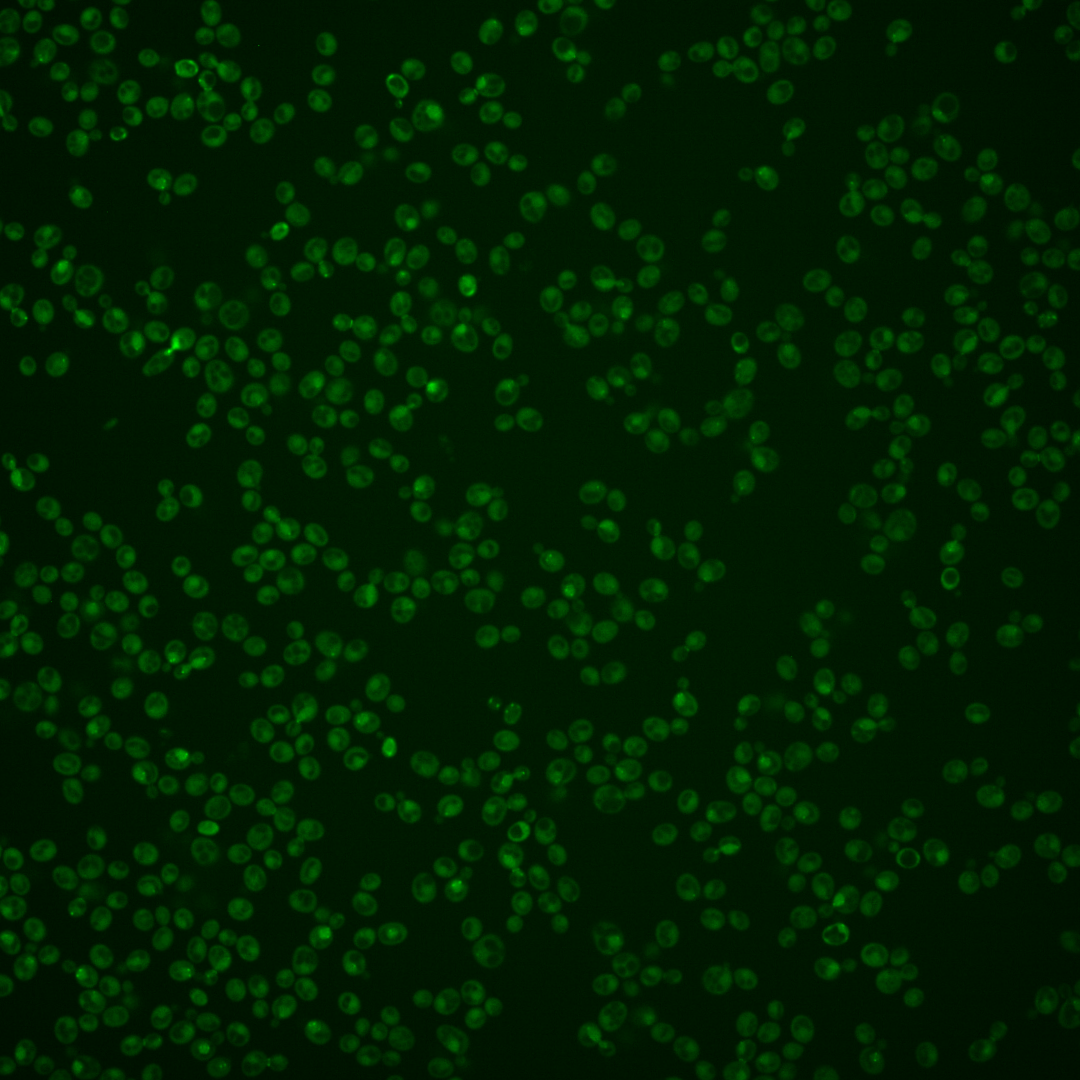
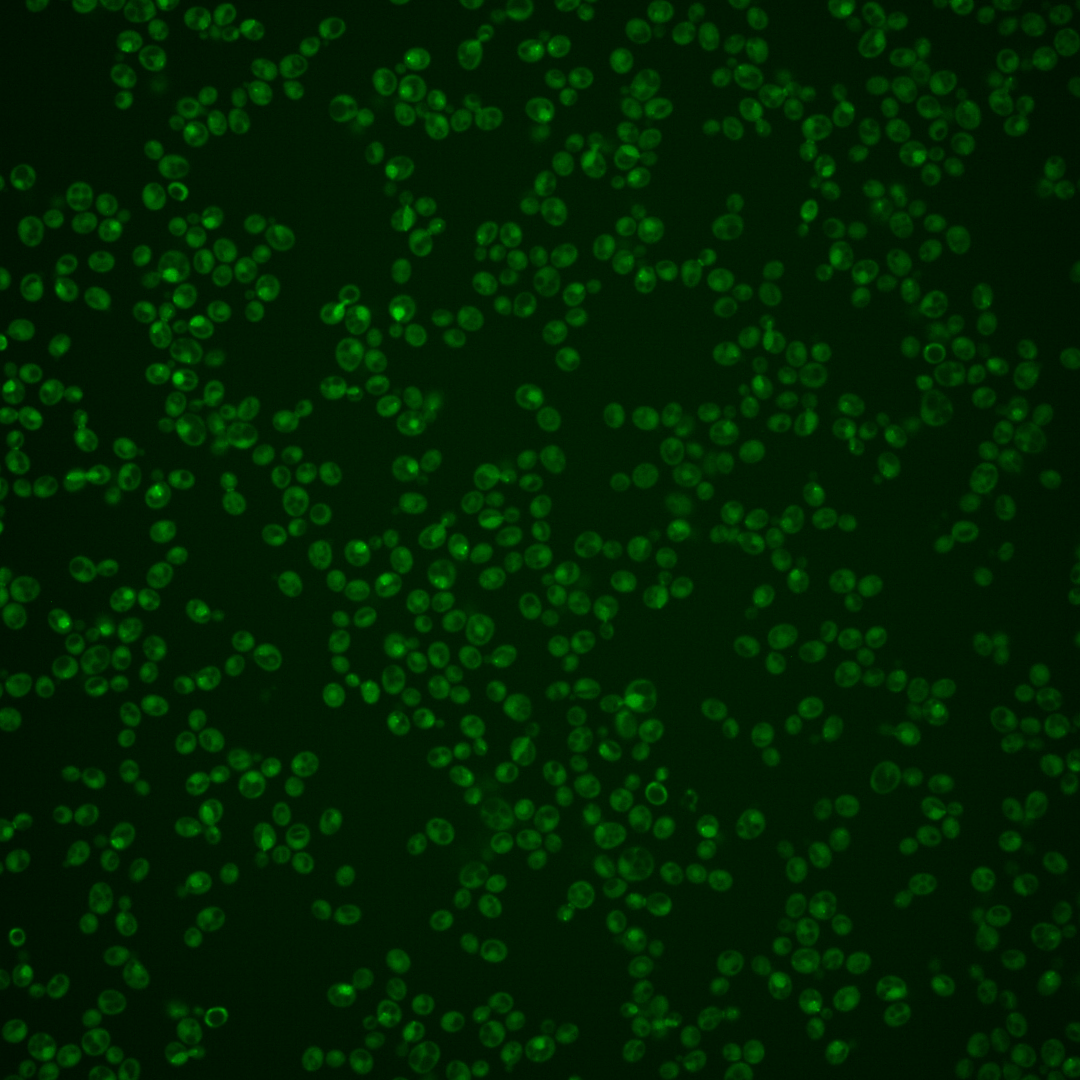
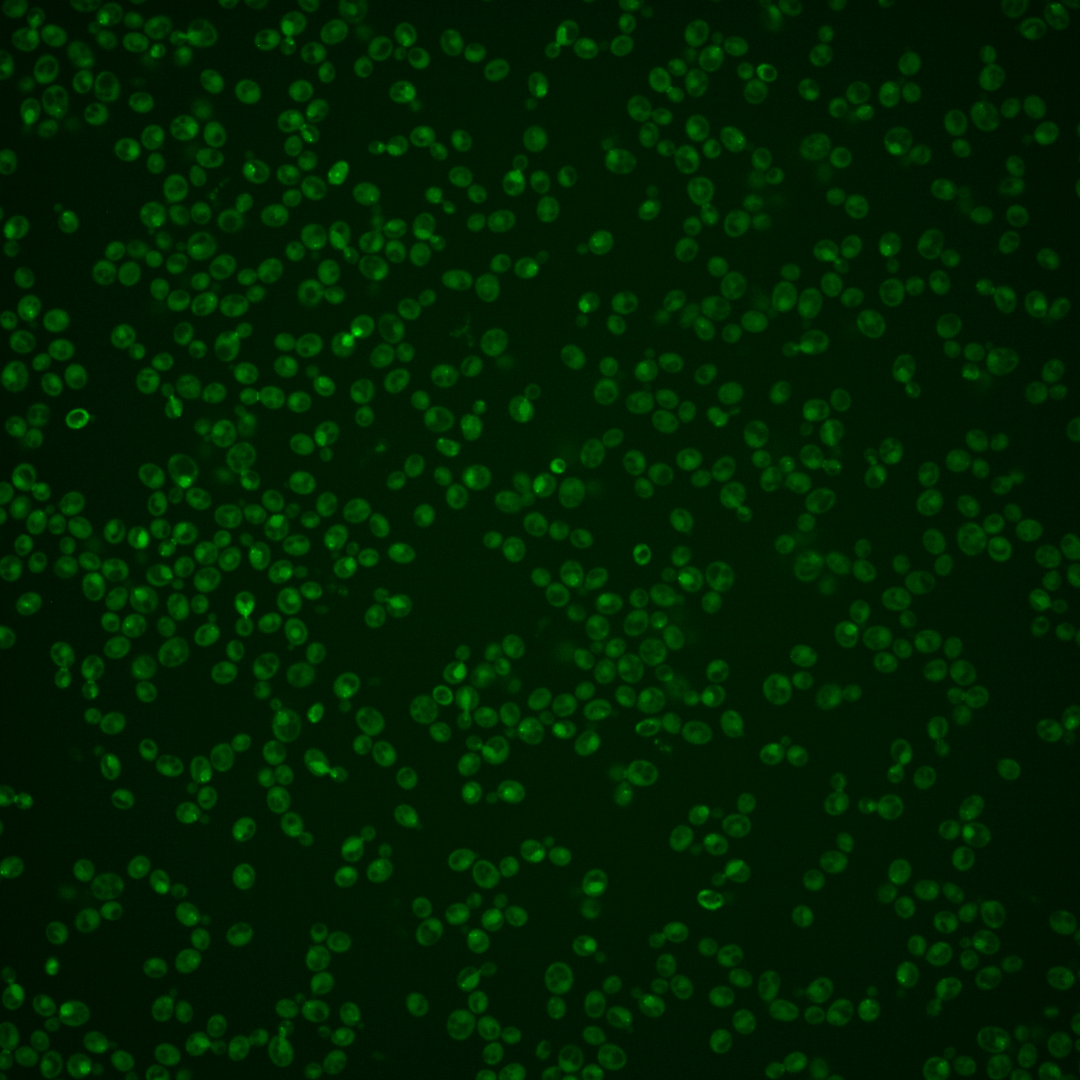

| Standard name | |
|---|---|
| Human Ortholog | |
| Description | Polo-like kinase; controls targeting and activation of Rho1p at cell division site via Rho1p guanine nucleotide exchange factors; regulates Spc72p; also functions in adaptation to DNA damage during meiosis; regulates the shape of the nucleus and expansion of the nuclear envelope during mitosis; similar to Xenopus Plx1 and S. pombe Plo1p; human homologs PLK1, PLK3 can each complement yeast cdc5 thermosensitive mutants |
Micrographs




















































































Sub-cellular Localization
Yeast GFP Assignment
Protein Abundance
Localization Change
External localization resources
| ensLOC | DeepLoc | |||||||||||||||||||||||
|---|---|---|---|---|---|---|---|---|---|---|---|---|---|---|---|---|---|---|---|---|---|---|---|---|
| Localization | WT1 | WT2 | WT3 | RAP60 | RAP140 | RAP220 | RAP300 | RAP380 | RAP460 | RAP540 | RAP620 | RAP700 | HU80 | HU120 | HU160 | rpd3Δ_1 | rpd3Δ_2 | rpd3Δ_3 | WT1 | WT2 | WT3 | AF100 | AF140 | AF180 |
| Cortical Patches | 1 | 1 | 7 | 2 | 7 | 0 | 3 | 2 | 1 | 2 | 1 | 1 | 2 | 0 | 0 | 0 | 1 | – | 0 | 2 | 4 | 2 | 6 | 4 |
| Bud | 0 | 0 | 3 | 5 | 15 | 7 | 13 | 15 | 18 | 17 | 22 | 13 | 3 | 1 | 0 | 0 | 0 | – | 10 | 14 | 23 | 4 | 6 | 5 |
| Bud Neck | 0 | 0 | 18 | 12 | 29 | 14 | 22 | 29 | 15 | 13 | 10 | 14 | 0 | 1 | 1 | 0 | 0 | – | 1 | 8 | 15 | 5 | 4 | 7 |
| Bud Site | 0 | 1 | 1 | 3 | 1 | 1 | 2 | 1 | 5 | 6 | 8 | 9 | 2 | 1 | 1 | 0 | 0 | – | – | – | – | – | – | – |
| Cell Periphery | 1 | 0 | 3 | 0 | 1 | 1 | 0 | 2 | 0 | 2 | 4 | 0 | 0 | 1 | 0 | 2 | 0 | – | 0 | 0 | 3 | 0 | 5 | 5 |
| Cytoplasm | 105 | 194 | 286 | 302 | 303 | 334 | 327 | 391 | 307 | 417 | 322 | 328 | 265 | 388 | 333 | 57 | 59 | – | 63 | 129 | 155 | 126 | 293 | 270 |
| Endoplasmic Reticulum | 3 | 4 | 8 | 1 | 3 | 4 | 1 | 0 | 0 | 0 | 0 | 0 | 0 | 0 | 2 | 4 | 5 | – | 1 | 0 | 2 | 1 | 8 | 2 |
| Endosome | 12 | 12 | 3 | 1 | 2 | 2 | 0 | 2 | 1 | 2 | 5 | 6 | 18 | 61 | 50 | 12 | 15 | – | 16 | 16 | 17 | 3 | 1 | 3 |
| Golgi | 0 | 0 | 0 | 1 | 0 | 0 | 0 | 0 | 0 | 0 | 0 | 0 | 0 | 1 | 0 | 2 | 2 | – | 2 | 2 | 0 | 0 | 1 | 0 |
| Mitochondria | 8 | 34 | 1 | 13 | 10 | 58 | 91 | 47 | 169 | 212 | 206 | 137 | 21 | 10 | 16 | 5 | 4 | – | 22 | 18 | 42 | 28 | 67 | 38 |
| Nucleus | 8 | 25 | 26 | 14 | 24 | 27 | 51 | 44 | 45 | 64 | 54 | 64 | 9 | 10 | 25 | 3 | 2 | – | 7 | 28 | 15 | 1 | 0 | 2 |
| Nuclear Periphery | 3 | 2 | 3 | 6 | 1 | 8 | 6 | 3 | 10 | 11 | 5 | 5 | 4 | 6 | 2 | 0 | 1 | – | 10 | 10 | 14 | 3 | 2 | 1 |
| Nucleolus | 17 | 5 | 3 | 6 | 13 | 9 | 9 | 2 | 16 | 16 | 31 | 17 | 17 | 27 | 21 | 3 | 6 | – | 2 | 4 | 3 | 1 | 0 | 0 |
| Peroxisomes | 1 | 0 | 0 | 0 | 0 | 0 | 0 | 0 | 1 | 1 | 0 | 2 | 2 | 1 | 4 | 0 | 0 | – | 1 | 0 | 1 | 0 | 0 | 0 |
| SpindlePole | 15 | 11 | 26 | 30 | 90 | 26 | 37 | 38 | 27 | 33 | 23 | 48 | 15 | 12 | 13 | 2 | 11 | – | 42 | 64 | 90 | 5 | 4 | 2 |
| Vac/Vac Membrane | 15 | 29 | 13 | 7 | 11 | 10 | 5 | 17 | 5 | 8 | 14 | 16 | 7 | 14 | 14 | 22 | 14 | – | 10 | 18 | 24 | 8 | 16 | 10 |
| Unique Cell Count | 163 | 293 | 382 | 370 | 456 | 452 | 493 | 535 | 502 | 664 | 583 | 570 | 340 | 493 | 453 | 98 | 98 | 199 | 328 | 434 | 196 | 433 | 358 | |
| Labelled Cell Count | 189 | 318 | 401 | 403 | 510 | 501 | 567 | 593 | 620 | 804 | 705 | 660 | 365 | 534 | 482 | 112 | 120 | 199 | 328 | 434 | 196 | 433 | 358 | |
Yeast GFP Assignment
Protein Abundance
| Screen | WT1 | WT2 | WT3 | RAP60 | RAP140 | RAP220 | RAP300 | RAP380 | RAP460 | RAP540 | RAP620 | RAP700 | HU80 | HU120 | HU160 | rpd3Δ_1 | rpd3Δ_2 | rpd3Δ_3 | AF100 | AF140 | AF180 |
|---|---|---|---|---|---|---|---|---|---|---|---|---|---|---|---|---|---|---|---|---|---|
| Mean Cell GFP Intensity (1e-4) | 4.3 | 3.9 | 4.7 | 4.3 | 4.9 | 3.7 | 3.8 | 4.2 | 3.4 | 3.3 | 3.3 | 3.8 | 3.9 | 4.0 | 4.2 | 6.4 | 6.2 | – | 3.7 | 3.5 | 3.8 |
| Std Deviation (1e-4) | 1.0 | 1.0 | 0.9 | 1.1 | 1.2 | 1.0 | 1.0 | 1.1 | 1.1 | 0.9 | 1.0 | 1.0 | 1.0 | 1.2 | 1.5 | 2.0 | 1.7 | – | 1.2 | 1.3 | 0.9 |
| Intensity Change (Log2) | – | – | – | -0.15 | 0.06 | -0.36 | -0.3 | -0.19 | -0.49 | -0.54 | -0.5 | -0.31 | -0.27 | -0.24 | -0.17 | 0.43 | 0.4 | – | -0.37 | -0.42 | -0.32 |
Localization Change
| Localization | RAP60 | RAP140 | RAP220 | RAP300 | RAP380 | RAP460 | RAP540 | RAP620 | RAP700 | HU80 | HU120 | HU160 | rpd3Δ_1 | rpd3Δ_2 | rpd3Δ_3 |
|---|---|---|---|---|---|---|---|---|---|---|---|---|---|---|---|
| Actin | – | – | – | – | – | – | – | – | – | – | – | – | – | – | – |
| Bud | – | – | – | – | – | – | – | – | – | – | – | – | 0 | 0 | – |
| Bud Neck | – | – | – | – | – | – | – | – | – | – | – | – | 0 | 0 | – |
| Bud Site | – | – | – | – | – | – | – | – | – | – | – | – | 0 | 0 | – |
| Cell Periphery | – | – | – | – | – | – | – | – | – | – | – | – | 0 | 0 | – |
| Cyto | – | – | – | – | – | – | – | – | – | – | – | – | – | – | – |
| Endoplasmic Reticulum | – | – | – | – | – | – | – | – | – | – | – | – | 0 | 0 | – |
| Endosome | – | – | – | – | – | – | – | – | – | – | – | – | 0 | 0 | – |
| Golgi | – | – | – | – | – | – | – | – | – | – | – | – | 0 | 0 | – |
| Mitochondria | – | – | – | – | – | – | – | – | – | – | – | – | 0 | 0 | – |
| Nuclear Periphery | – | – | – | – | – | – | – | – | – | – | – | – | 0 | 0 | – |
| Nuc | – | – | – | – | – | – | – | – | – | – | – | – | – | – | – |
| Nucleolus | – | – | – | – | – | – | – | – | – | – | – | – | 0 | 0 | – |
| Peroxisomes | – | – | – | – | – | – | – | – | – | – | – | – | 0 | 0 | – |
| SpindlePole | – | – | – | – | – | – | – | – | – | – | – | – | 0 | 0 | – |
| Vac | – | – | – | – | – | – | – | – | – | – | – | – | – | – | – |
| Cortical Patches | – | – | – | – | – | – | – | – | – | – | – | – | 0 | 0 | – |
| Cytoplasm | – | – | – | – | – | – | – | – | – | – | – | – | 0 | 0 | – |
| Nucleus | – | – | – | – | – | – | – | – | – | – | – | – | 0 | 0 | – |
| Vacuole | – | – | – | – | – | – | – | – | – | – | – | – | 6.5 | 4.2 | – |
External localization resources
Images






























Protein Concentration and Protein Localization Data
| R1 | R2 | R3 | ||||||||||||||||
|---|---|---|---|---|---|---|---|---|---|---|---|---|---|---|---|---|---|---|
| G1 Pre-START | G1 Post-START | S/G2 | Metaphase | Anaphase | Telophase | G1 Pre-START | G1 Post-START | S/G2 | Metaphase | Anaphase | Telophase | G1 Pre-START | G1 Post-START | S/G2 | Metaphase | Anaphase | Telophase | |
| Concentration | -0.569 | -0.2468 | 0.0053 | 1.3495 | 1.0737 | -0.4586 | -0.6765 | -0.3299 | 0.0187 | 0.9773 | 1.1029 | -0.5358 | -0.869 | 0.1332 | 0.0899 | 1.1084 | 1.7813 | -0.4957 |
| Actin | 0.012 | 0.0008 | 0.0055 | 0.0134 | 0.0054 | 0.0018 | 0.0386 | 0.0047 | 0.0157 | 0.0017 | 0.004 | 0.0066 | 0.0278 | 0.0018 | 0.0213 | 0.0386 | 0.0114 | 0.0052 |
| Bud | 0.0015 | 0.0037 | 0.0021 | 0.0024 | 0.0006 | 0.0009 | 0.0021 | 0.0034 | 0.0009 | 0.0002 | 0.0004 | 0.0015 | 0.0033 | 0.0041 | 0.0005 | 0.0005 | 0.0007 | 0.0009 |
| Bud Neck | 0.017 | 0.0069 | 0.0058 | 0.0272 | 0.0693 | 0.0826 | 0.0293 | 0.0015 | 0.0098 | 0.0163 | 0.0898 | 0.1015 | 0.006 | 0.0007 | 0.0013 | 0.0019 | 0.1315 | 0.1484 |
| Bud Periphery | 0.0039 | 0.0037 | 0.0024 | 0.0027 | 0.0017 | 0.0012 | 0.0027 | 0.0034 | 0.0014 | 0.0009 | 0.0013 | 0.0031 | 0.0076 | 0.0043 | 0.0009 | 0.001 | 0.0023 | 0.0025 |
| Bud Site | 0.0067 | 0.0168 | 0.0209 | 0.0091 | 0.0018 | 0.0019 | 0.033 | 0.029 | 0.0049 | 0.0003 | 0.0016 | 0.0004 | 0.0087 | 0.0078 | 0.0161 | 0.0022 | 0.0023 | 0.0014 |
| Cell Periphery | 0.0006 | 0.0004 | 0.0004 | 0.0003 | 0.0003 | 0.0002 | 0.0007 | 0.0004 | 0.0002 | 0.0001 | 0.0003 | 0.0002 | 0.0006 | 0.0003 | 0.0002 | 0.0002 | 0.0006 | 0.0003 |
| Cytoplasm | 0.0662 | 0.0744 | 0.0365 | 0.0401 | 0.0444 | 0.0974 | 0.0819 | 0.09 | 0.0241 | 0.008 | 0.0325 | 0.2011 | 0.0501 | 0.1141 | 0.0355 | 0.0047 | 0.0081 | 0.1327 |
| Cytoplasmic Foci | 0.0644 | 0.0191 | 0.0504 | 0.007 | 0.0127 | 0.0329 | 0.0823 | 0.0452 | 0.1012 | 0.0021 | 0.0206 | 0.0266 | 0.1112 | 0.0353 | 0.062 | 0.0039 | 0.0216 | 0.0328 |
| Eisosomes | 0.0003 | 0.0001 | 0.0002 | 0 | 0.0001 | 0.0001 | 0.0006 | 0.0001 | 0.0002 | 0.0001 | 0.0001 | 0.0002 | 0.0003 | 0.0001 | 0.0001 | 0.0002 | 0.0002 | 0.0001 |
| Endoplasmic Reticulum | 0.0096 | 0.0057 | 0.0036 | 0.0047 | 0.0049 | 0.0047 | 0.0063 | 0.0026 | 0.0029 | 0.0029 | 0.0075 | 0.0048 | 0.0075 | 0.0045 | 0.0022 | 0.0032 | 0.0057 | 0.0032 |
| Endosome | 0.0296 | 0.0064 | 0.0177 | 0.0113 | 0.018 | 0.0098 | 0.0282 | 0.0047 | 0.0283 | 0.0051 | 0.0666 | 0.0096 | 0.0403 | 0.0143 | 0.0149 | 0.0064 | 0.0426 | 0.012 |
| Golgi | 0.0028 | 0.0004 | 0.0042 | 0.0044 | 0.0068 | 0.0011 | 0.0145 | 0.0012 | 0.0121 | 0.0002 | 0.0067 | 0.001 | 0.0065 | 0.0075 | 0.0066 | 0.0059 | 0.0095 | 0.0024 |
| Lipid Particles | 0.0198 | 0.0035 | 0.0163 | 0.0048 | 0.0399 | 0.0059 | 0.05 | 0.0056 | 0.0239 | 0.0025 | 0.0229 | 0.0046 | 0.0552 | 0.0059 | 0.0287 | 0.0173 | 0.052 | 0.0077 |
| Mitochondria | 0.0061 | 0.0013 | 0.0035 | 0.002 | 0.012 | 0.0015 | 0.0095 | 0.0035 | 0.0165 | 0.0018 | 0.0036 | 0.0013 | 0.0131 | 0.0031 | 0.0043 | 0.0049 | 0.0182 | 0.0013 |
| None | 0.556 | 0.548 | 0.2642 | 0.008 | 0.0427 | 0.5885 | 0.4386 | 0.499 | 0.1357 | 0.0049 | 0.0049 | 0.5109 | 0.4173 | 0.4429 | 0.211 | 0.0026 | 0.0034 | 0.5522 |
| Nuclear Periphery | 0.0686 | 0.0609 | 0.1409 | 0.2659 | 0.2529 | 0.0305 | 0.047 | 0.0762 | 0.1182 | 0.3741 | 0.2981 | 0.0329 | 0.0692 | 0.0744 | 0.1526 | 0.2888 | 0.367 | 0.0249 |
| Nucleolus | 0.0157 | 0.0088 | 0.0185 | 0.0106 | 0.0295 | 0.0081 | 0.0071 | 0.0066 | 0.0086 | 0.0108 | 0.0253 | 0.003 | 0.0078 | 0.0066 | 0.0099 | 0.0087 | 0.037 | 0.0031 |
| Nucleus | 0.0545 | 0.1573 | 0.1886 | 0.4433 | 0.2816 | 0.0619 | 0.0229 | 0.136 | 0.1246 | 0.5045 | 0.2497 | 0.0378 | 0.0233 | 0.1329 | 0.1418 | 0.4609 | 0.128 | 0.028 |
| Peroxisomes | 0.0067 | 0.0015 | 0.003 | 0.0014 | 0.0249 | 0.0012 | 0.025 | 0.0029 | 0.0154 | 0.0002 | 0.0027 | 0.0032 | 0.0326 | 0.0011 | 0.0087 | 0.0083 | 0.0206 | 0.0028 |
| Punctate Nuclear | 0.034 | 0.0723 | 0.2072 | 0.1359 | 0.1374 | 0.0617 | 0.0695 | 0.0785 | 0.3486 | 0.0502 | 0.144 | 0.0418 | 0.0939 | 0.1321 | 0.2756 | 0.1331 | 0.1155 | 0.0338 |
| Vacuole | 0.0159 | 0.006 | 0.0043 | 0.0024 | 0.0053 | 0.0046 | 0.0068 | 0.0035 | 0.0035 | 0.0041 | 0.009 | 0.0056 | 0.0111 | 0.0039 | 0.0023 | 0.0017 | 0.008 | 0.0029 |
| Vacuole Periphery | 0.0081 | 0.002 | 0.0039 | 0.003 | 0.0077 | 0.0018 | 0.0035 | 0.002 | 0.0033 | 0.0092 | 0.0083 | 0.0024 | 0.0065 | 0.0024 | 0.0034 | 0.0052 | 0.0138 | 0.0015 |
Sequencing Data
| R1 | R2 | |||||||||
|---|---|---|---|---|---|---|---|---|---|---|
| G1 Post-START | S/G2 | Metaphase | Anaphase | Telophase | G1 Post-START | S/G2 | Metaphase | Anaphase | Telophase | |
| Gene Expression | 8.075 | 53.0911 | 50.4544 | 40.0409 | 19.5882 | 8.8515 | 57.5651 | 72.9379 | 44.9577 | 22.6008 |
| Translational Efficiency | 1.0927 | 0.9682 | 0.9339 | 0.7645 | 0.6557 | 0.8499 | 0.909 | 0.693 | 0.8939 | 0.7558 |
Hit Data
| Dataset | Hit |
|---|---|
| Protein Concentration | ✔ |
| Protein Localization | ✘ |
| Gene Expression | ✔ |
| Translational Efficiency | ✘ |
Endocytosis
| Temp | Actin Patch (Sac6-tdTomato) | Cortical Patch (Sla1-GFP) | Late Endosome (Snf7-GFP) | Vacuole (Vph1-GFP) |
|---|---|---|---|---|
| 37℃ | ||||
| RT |
Cell Cycle Omics
CYCLoPs (Cdc5-GFP)
| Gene / Allele | Actin Patch (Sac6-tdTomato) | Cortical Patch (Sla1-GFP) | Late Endosome (Snf7-GFP) | Vacuole (Sac6-tdTomato) |
|---|
| Gene | Images |
|---|
| Gene | Images |
|---|
Images are not yet available
Images are not yet available